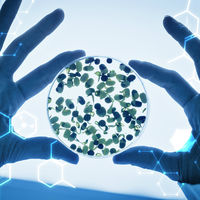

Медицинский центр MEDCLINIC ЗДОРОФФ в справочнике BLIZKO.ru
- Медицинские лаборатории
- Поликлиники (частные и государственные)
- Консультативно-диагностические центры
- Медицинские центры
MEDCLINIC ЗДОРОФФ
Более 5 лет на рынке медицинских и лабораторных услуг. Короткие сроки выполнения анализов. Выгодные цены (дисконтная система). Выезд на дом. Результаты на электронный ящик. График с Пн-Пт 6:45-19:30, Сб 8-17, Вс 8-13. Рядом с остановкой Электротехников.
Наши преимущества
Наши преимущества:
* Гарантированное качество за счет выбора одних из лучших технологий лабораторной диагностики среди различных лабораторий.
* Широкий спектр лабораторных исследований.
* Короткие сроки выполнения анализов.
* Индивидуальный подход к каждому пациенту.
* Вежливый, доброжелательный, высококвалифицированный медицинский персонал.
* Выезд на дом.
* Возможность получения результатов анализов на электронный ящик
* Удобная форма оплаты: за наличный и безналичный расчет.
* Удобный для населения график работы – с понедельника по пятницу с 6.45 до 19.30, в субботу с 8.00 до 17.00, в воскресенье с 8.00 до 13.00.
* Выгодные цены, гибкие системы скидок, как для льготной категории граждан, так и для постоянных клиентов.
* Удобное месторасположение - рядом с остановкой "Электротехников"
Статьи:
Профессиональная помощь с психосоматикой.
Наши предложенияМы рекомендуем
-
Цена:3 800 руб./процедураИССЛЕДУЕМЫЙ БИОМАТЕРИАЛ материал СРОК ИСПОЛНЕНИЯ 10 Цена по дисконтной карте 3230
-
Цена:780 руб./процедураИССЛЕДУЕМЫЙ БИОМАТЕРИАЛ кровь (ЭДТА) СРОК ИСПОЛНЕНИЯ 2-3 Цена по дисконтной карте 663
-
Цена:430 руб./услугаЭто широко распространенный метод диагностики. Он не подвергает пациента лучевой нагрузке и считается безвредным.
-
Цена:400 руб./услугаЭто широко распространенный метод диагностики. Он не подвергает пациента лучевой нагрузке и считается безвредным.
-
Цена:400 руб./услугаЭто широко распространенный метод диагностики. Он не подвергает пациента лучевой нагрузке и считается безвредным.
-
Цена:550 руб./услугаЭто широко распространенный метод диагностики. Он не подвергает пациента лучевой нагрузке и считается безвредным.
Все предложения (500)
Тип компании
- Поставщик услуг. Сервис
Отзывы
Новый отзыв о компании MEDCLINIC ЗДОРОФФ
В "Здорофф" попала по направлению врача-эндокринолога для сдачи гормонов щитовидной железы. Резул...
Контактная информация
- Написать нам
- г Набережные Челны, пр-кт Набережночелнинский, д. 51
Показать на карте
Время работы
- пн-пт 7:00-19:00
- сб 8:00-17:00
- вс 8:00-13:00